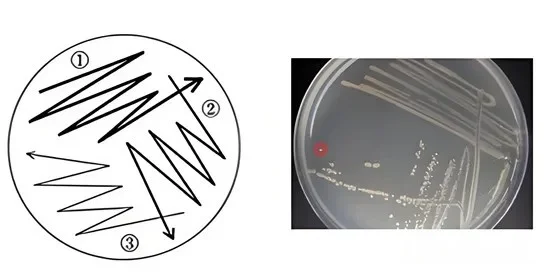
三区平板划线图 三区平板划线图
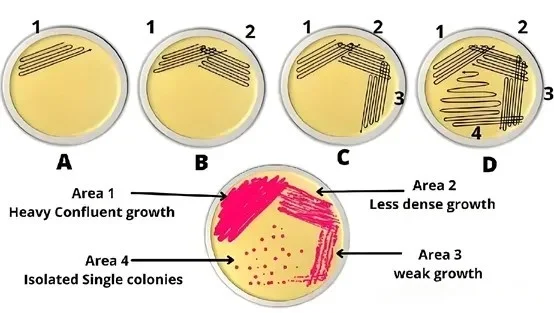
四区平板划线图 四区平板划线图

手把手教你:一皿一线,细菌“排排坐”!
发布时间:2025-09-11 浏览次数:1998
一、为什么要进行平板划线?
对于在-80℃保存时间较久的甘油菌,有可能出现以下情况:(1)被杂菌污染;(2)目的菌质粒丢失;(3)目的菌活性变低。所以,需要通过平板划线、筛选培养,重新获得高活性的单个目的菌。
二、如何进行平板划线?
1、三区平板划线:将平板划分为三个逐渐缩小的区域,接种环依次密集到稀疏划线,并与前一区轻微搭接,通过逐级稀释在第三区获得单菌落,常用于临床标本的首次分离,尤其适合菌量不高的样品。
2、四区平板划线:在三区基础上增加一个区域,四个区域依次递减、轻微搭接,稀释效果更彻底,能进一步降低菌量密度,适合污染严重或菌量高的样品,提高纯培养的成功率。
3、单次连续之字划线:接种环从平板一端到另一端连续划“之”字,不交叉、不重复,使菌液沿全程均匀分布,适合菌量已知的纯培养或增菌液接种;也可用于混合样本分离,但稀释梯度不如分区划线明显,获得单菌落的概率相对较低。

4、网状平板划线:先做一次“之”字划线,再将平板旋转90°进行垂直划线,形成交叉网格,增加划线面积和稀释机会,适合生长缓慢或菌落细小的微生物分离,但交叉处菌落可能过密。
三、三区平板划线操作步骤
1、 左手拿培养皿,右手持接种环,打开盖子一条缝隙,将沾菌接种环在平皿边缘“之”字划第一区域(约 1/4~1/5 面积)。
2、 转动培养皿约 120°,灼烧冷却接种环,从第一区末端带菌在第二区划线。
3、 再转动培养皿约 120°,灼烧冷却接种环,从第二区末端带菌在第三区划线。
⚠️ 注意:各区划线仅与前一区少量相交,绝不与其他区域重叠;全程应在超净工作台中进行。
四、常见问题及解决办法
1、菌落连成一片(“草坪”)
原因:菌量过大或划线过密,稀释梯度不足。
解决:甘油菌先 10⁻⁴~10⁻⁵ 稀释;第二、三区再稀疏些;必要时改用四区法。
2、平板无菌落
原因:菌已失活或接种量过少;抗性平板选错抗生素;培养条件不符。
解决:换用新鲜甘油菌、降低抗生素浓度、检查培养温度/气体条件。
3、杂菌覆盖目的菌
原因:甘油菌污染或操作污染。
解决:重新划线时加入目的菌特需抗性/显色底物;操作前用75%酒精擦拭工作台并紫外再照15 min;必要时用无菌滤纸贴盖法二次纯化。
4、 单菌落过少或分布不均
原因:接种环未充分冷却杀死部分菌;旋转角度不足导致稀释梯度不足。
解决:灼烧后冷却 5–10 s;确保每区旋转≈120°;可在第三区尾端再轻划两条补充线。
本文来源于网络,版权归原作者所有,仅供学习参考,如有侵权请联系删除!
